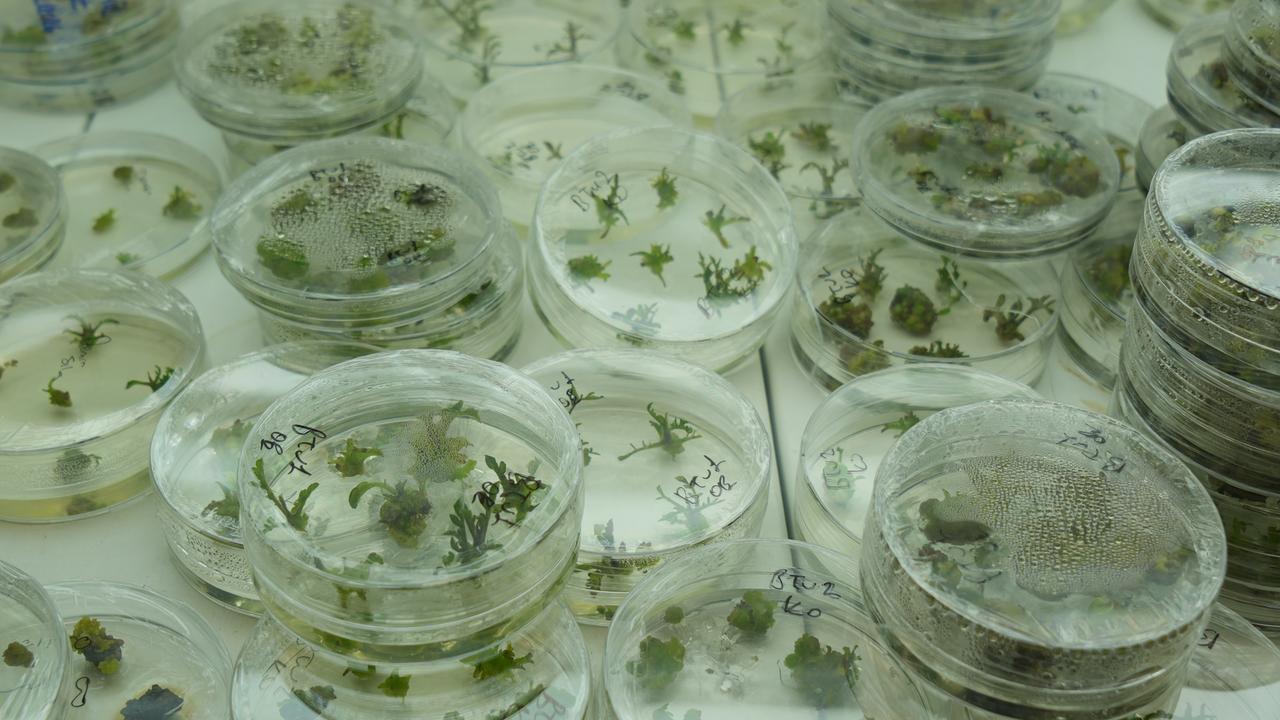

Ondokuz Mayıs Üniversitesi (OMÜ) Ziraat Fakültesi’nde yürütülen bir doktora çalışması, iklim değişikliğinin tarım üzerindeki etkilerine karşı dikkat çekici bir çözüm arayışını ortaya koyuyor. Pakistanlı doktora öğrencisi Momna Mehmood tarafından yürütülen araştırmada kuraklığa daha dayanıklı domates çeşitlerinin geliştirilmesi hedefleniyor.
OMÜ Ziraat Fakültesi Tarımsal Biyoteknoloji Bölümü Öğretim Üyesi Prof. Dr. Musa Kavas danışmanlığında yürütülen çalışmada, özellikle su kaynaklarının azalmasıyla birlikte üretimi zorlaşan domates bitkisinin kuraklığa karşı verdiği biyolojik tepkiler detaylı şekilde inceleniyor.
Kuraklığa Dayanıklı Domates İçin Kritik Araştırma
Araştırma kapsamında daha önce geliştirilen ve gen düzenleme yöntemiyle elde edilen “J-03” isimli özel domates hattı mercek altına alındı. Çalışmada bu domateslerin kuraklık altında hangi genleri devreye soktuğu, stres koşullarına nasıl tepki verdiği ve diğer domates çeşitlerinden hangi yönleriyle ayrıldığı araştırılıyor.
Proje kapsamında hem normal domates bitkileri hem de gen düzenlemesi yapılmış hatlar karşılaştırılarak kuraklığa dayanıklılığı artıran biyolojik mekanizmalar ortaya çıkarılmaya çalışılıyor. Laboratuvar analizleri ve bitkiler üzerinde yapılan ölçümler sayesinde kuraklık stresine verilen tepkiler ayrıntılı biçimde değerlendiriliyor.
Su Kaybını Azaltacak Gen Düzenlemeleri Hedefleniyor
Araştırmaya ilişkin değerlendirmelerde bulunan Prof. Dr. Musa Kavas, domates üretiminde kuraklığın en önemli risklerden biri olduğunu vurguladı. Küresel ısınma ile birlikte yağış rejimlerinde önemli değişimler yaşandığını belirten Kavas, bu durumun bitkisel üretimi doğrudan etkilediğini ifade etti.
Kavas, özellikle açık arazide yapılan domates üretiminin büyük ölçüde yağışa bağlı olduğunu belirterek kurak dönemlerde ciddi verim kayıpları yaşanabildiğini söyledi.
Laboratuvarlarında genom düzenleme projeleri yürüttüklerini belirten Kavas, CRISPR olarak adlandırılan gen düzenleme tekniğini kullanarak domatesin suyu daha verimli kullanmasını sağlayacak çalışmalar yaptıklarını dile getirdi.
Hedef Daha Az Su İle Üretim
Kavas, yapılan çalışmalarda bitkinin kök yapısında değişiklikler yapmayı ve yapraklardan gerçekleşen su kaybını azaltmayı hedeflediklerini ifade ederek daha önce yapılan bazı araştırmalarda olumlu sonuçlar elde edildiğini söyledi.
Özellikle kök sayısının artırılmasının domatesin kuraklığa karşı daha dayanıklı hale gelmesini sağladığını belirten Kavas, temel hedeflerinin stres koşullarında dahi üretimde düşüş yaşanmayan domates çeşitleri geliştirmek olduğunu vurguladı.
Araştırmayı yürüten Pakistanlı doktora öğrencisi Momna Mehmood ise çalışmanın başarılı olması halinde domates üretimi açısından çok önemli bir bilimsel katkı sağlanacağını belirterek, “Bu proje başarılı olursa domateste çok yeni bir şey olacak ve literatüre önemli bir katkı sağlayacak” dedi.